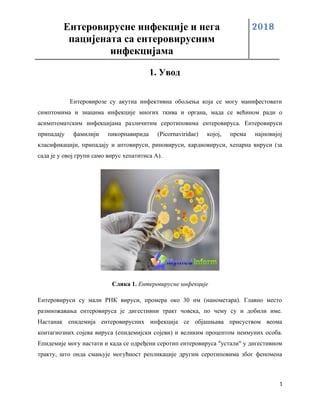
Enterovirusne infekcije i nega pacijenata sa enterovirusnim infekcijama

Genitalni sistem
genitalni sistem
HPV
patologija
Visoka medicinska škola strukovnih studija
DOCX · 13 str.
Pogledaj